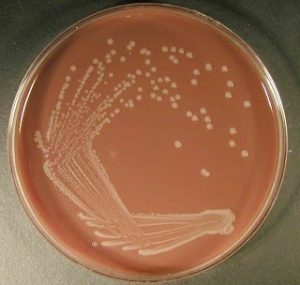
Haemophilus influenzae on chocolate agar - Haemophilus influenzaeon chocolate agar

Chocolate Agar (CAP or CHOC) is a nonselective, enriched medium used for the isolation and identification of fastidious pathogens. Heating of blood agar produces this agar. This in turn ruptures the red blood cell (RBC) and releases nutrients aiding in the growth of fastidious bacteria, most notablyHaemophilus and Neisseriaspecies. The name is derived from the fact that the lysis of RBC gives the medium a chocolate-brown color.
Principle
In-house prepared chocolate agar is modification of blood agar by heating to lyze the RBC. The lysis of RBC releases intracellular nutrients such as hemoglobin, hemin (X factor), and the coenzyme nicotinamide adenine dinucleotide (NAD or V factor) into the agar for utilization by fastidious bacteria. Peptone provides the organism with nitrogen, amino acids, and other elements essential for growth, sodium chloride maintains the osmotic balance, and agar acts as a solidifying agent.
In commercial preparation, casein and animal tissue digest provides the organism with nitrogen, amino acids, and other elements. Since Neisseria species are highly sensitive to toxic substances such as fatty acids; addition of cornstarch neutralizes possible toxic metabolites. Potassium phosphate helps to maintain a uniform pH during growth. Hemoglobin solution provides X factor (hemin) required by Haemophilus species, and isovitox enrichment provides V-factor (nicotinamide dinucleotide), and other complex compounds that enhance the growth ofNeisseria species.
Composition of Chocolate Agar
The composition of chocolate agar is the same as that of blood agar. The only difference is blood agar is heated in a water bath to prepare chocolate agar. Commercially available chocolate agar medium, however, has a different composition and requires no addition of blood
| Ingredients | Gm/L |
|---|---|
| Casein/animal tissue digest | 15.0 |
| Cornstarch | 1.0 |
| Potassium phosphate, dibasic | 4.0 |
| Potassium phosphate, monobasic | 1.0 |
| Sodium chloride | 5.0 |
| Agar | 10.0 |
| Hemoglobin solution (2%) | 500.0 ml |
| Isovitox enrichment | 10.0 ml |
Preparation of Chocolate Agar
- Prepare the blood agar base as instructed by the manufacturer.
- Sterilize by autoclaving at 121°C for 15 minutes.
- Add 5-7% v/v of defibrinated blood (horse or sheep blood). Then place the media in a water bath of 75 -80°C.Keep swirling gently until the color changes to dark brown.
- Pour into sterile Petri plates under aseptic conditions after the media has cooled to 50-55°C.
- Label the plates with the name of the media, and date of preparation, and store them invertedly at 2-8°C until use.

Note: Other supplements such as isovitalex could be added during preparation.
Chocolate agar slants
- Dispense 4 mL of the medium into 16X125 mm screw-cap tubes
- Keep the tubes in a slanted position and let them solidify.
This agar slants appear brown to brownish-red color. Store these at 4°C when not in use and warmed to room temperature (25°C) before use.
Colony Morphology
Almost all organisms grow on this agar giving grey colonies of various sizes. However, it’s use is specifically to isolate fastidious pathogens such as Neisseria and Haemophilus, their colony morphologies are below.
| Organism | Colony morphology |
|---|---|
| Neisseria gonorrhoeae | pinkish-brown and translucent, exhibit smooth consistency and defined margins, and are typically 0.5-1 mm in diameter |
| N. meningitidis | grayish, non-hemolytic, round, convex, smooth, moist, glistening colonies with a clearly defined edge, larger in size as compared to N. gonorrhoeae |
| Haemophilus influenzae | Nonhemolytic, colorless, moist colonies with a characteristic “mousy” odor. |
Quality Control
Perform sterility testing of the prepared media by incubating 3-5 uninoculated plates of each batch at 37°C for 18-24 hours. Regard any growth as positive, and discard the whole lot.
| Organism | Expected Result |
|---|---|
| Neisseria gonorrhoeae ATCC 43069 | Luxuriant growth, small, grey to white colonies |
| Haemophilus influenzae ATCC 10211 | Good growth, small, colorless, moist colonies |
Performance testing of the media should be done by inoculating the following organisms to prepared plates. Then incubating them for 18-24 hours at 35-37°C with 5% CO2 (or in a candle jar but it can only provide up to 3% CO2). This helps to determine the growth performance of the completed medium
Uses of Chocolate Agar
- To isolate fastidious organisms such as H. influenzae, N. gonorrhoeae,andN. menigitidis from various clinical specimens. This aids in the diagnosis of disease.
- Chocolate agar with bacitracin acts as a selective medium for screening H. influenzaefrom specimens e.g. sputum containing a mixed flora of microorganisms
Limitations
- Since this agar is an enriched medium, contamination occurs easily.
- Use of this agar only, makes it difficult to differentiate non-pathogenic organisms from pathogenic ones as the former overgrow pathogenic bacteria.
- It has a reduced concentration of agar, so the surface of the plate is fragile and prone to scratches during streaking.
Modifications of Chocolate Agar
- Thayer-Martin Media: It is a modification of chocolate agar supplemented with vancomycin, nystatin, and colistin. It helps to inhibit the normal flora, including nonpathogenic Neisseria for the selective isolation of N. gonorrhoeae and N. meningitidis.
- Chocolate Agar with bacitracin: This modification is useful as a selective medium to improve the primary isolation of H. influenzae from specimens such as sputum. As they may contain a mixed flora of bacteria and/or fungi.
- Chocolate agar with GC base and growth supplement: This variant of chocolate agar is used to support the special growth requirements (hemin and NAD). It is needed for the isolation of Haemophilus spp. when incubated at 35-37°C in a 5% CO2 atmosphere.
- Chocolate agar with TSA and growth supplements: It is a modification of chocolate agar that supports the special growth requirements (hemin and NAD) needed for the isolation of fastidious organisms such as H. influenzae when incubated at 35-37°C in a 5% CO2 atmosphere.
References
- Madigan Michael T, Bender, Kelly S, Buckley, Daniel H, Sattley, W. Matthew, & Stahl, David A. (2018). Brock Biology of Microorganisms (15th Edition). Pearson.
- Color Atlas and Textbook of Diagnostic Microbiology, Koneman, 5th edition